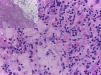

La fascitis eosinofílica es una enfermedad rara del tejido conectivo que se caracteriza por induración y engrosamiento progresivo y simétrico de la piel y del tejido celular subcutáneo localizado, principalmente, en las extremidades. Además de las manifestaciones cutáneas hay compromiso articular, muscular y, en casos excepcionales, compromiso sistémico. Su diagnóstico se basa en los hallazgos clínicos, eosinofilia en sangre periférica y la toma de una biopsia profunda de piel, que incluya la fascia donde se evidencia un infiltrado compuesto por linfocitos y eosinófilos. El tratamiento de elección son los esteroides sistémicos acompañados de medicamentos inmunosupresores.
Eosinophilic fasciitis is a rare connective tissue disease. It is characterised by a progressive and symmetrical induration and thickening of the skin and soft tissues of the limbs. In addition to the skin manifestations, the joints and muscles are also involved, and in rare cases there can be systemic involvement. The diagnosis of EF is based on clinical findings, the presence of peripheral blood eosinophilia, and a full-thickness biopsy that should include the deep fascia in order to show the inflammatory infiltration that is mostly composed of lymphocytes and eosinophils.
Systemic corticosteroids remain the treatment of choice and may be combined with an immunosuppressive drug.
La fascitis eosinofílica (FE) es una enfermedad rara del tejido conectivo que se caracteriza por edema, induración y engrosamiento de la piel y tejidos blandos1. Afecta por igual a hombres y mujeres y la causa es desconocida2,3. El diagnóstico definitivo se hace con biopsia de piel que incluya tejido celular subcutáneo y biopsia de fascia muscular. A continuación presentamos el caso clínico de una paciente femenina de 57 años de edad con compromiso extenso consistente en edema, induración y limitación funcional con una respuesta refractaria al tratamiento.
Reporte de casoPaciente de sexo femenino, de 57 años de edad, con un cuadro clínico de un mes y medio de evolución consistente en la induración de la piel en región proximal de las extremidades, abdomen y cuello, asociado a dolor a la palpación la cual progresa hasta la limitación funcional. Adicionalmente, la paciente presentaba caída del cabello, artralgias y edema en miembros inferiores. Como antecedentes patológicos de importancia la paciente tenía un diagnóstico de esferocitosis hereditaria que requirió esplenectomía a los 17 años de edad, estando desde entonces en remisión.
Al examen físico presentaba livedo reticularis en miembros inferiores (fig. 1), así como induración, la cual afectaba la cara interna de los muslos, hemiabdomen inferior y miembros superiores, siendo el miembro superior derecho el sitio donde se presentaba con mayor intensidad con cambios en piel de naranja (fig. 2) y una depresión longitudinal en la cara ventral (fig. 3) pero sin afectar la región de la piel distal a la muñeca.
Ante el compromiso generalizado y la sospecha de una enfermedad sistémica, la paciente fue hospitalizada. Dentro de los exámenes de laboratorio realizados, el hemograma de ingreso mostró una leucocitosis de 17.430 leucocitos/mm3 a expensas de eosinófilos con un valor absoluto de 4.183 (25,8%), los cuales aumentaron hasta llegar a un valor absoluto de 5.670 eosinófilos/mm3 (32,8%) (fig. 4). Adicionalmente, la paciente tenía una velocidad de sedimentación globular de 18mm/hora, anticuerpos antinucleares realizados por inmunofluorescencia indirecta en células HEP 2 de 1:320 patrón homogéneo y unos antígenos nucleares extractables (Ro, La, Sm, RNP) negativos por técnica ELISA. Dentro de los estudios imagenológicos, se realizaron una tomografía de abdomen que reportó hepatomegalia y una tomografía de tórax y ecografía doppler de miembros inferiores, ambas normales. Para caracterizar mejor el compromiso se solicitó una resonancia magnética de antebrazo derecho que reportó edema de los tejidos blandos, afectando toda la extremidad y engrosamiento de la fascia con aumento de la captación del medio de contraste a este nivel. Ante estos hallazgos, a la paciente se le realizó una biopsia cutánea inicial que incluyó epidermis y dermis sin alteraciones. Posteriormente, se llevó a una biopsia de mayor profundidad, esta vez con representación de tejido celular subcutáneo y fascia muscular en la que se demostró engrosamiento de la fascia, depósito de fibrina e infiltrado inflamatorio compuesto por linfocitos y eosinófilos (fig. 5) realizándose el diagnóstico de FE.
La paciente recibió manejo con esteroides iniciando a dosis de 1mg/kg con posterior descenso y metotrexate 15mg/semana con empeoramiento de la enfermedad a pesar de estos tratamientos. Ante esta situación, se decidió dar manejo nuevamente con esteroides, inicialmente con pulsos de metilprednisolona 500mg/día durante tres días y posteriormente se continuó con prednisolona 50mg/día durante un mes con posterior descenso, acompañado de ciclofosfamida mensual intravenosa a dosis de 750 a 1 gramo mensual, para una dosis acumulada de 5 g y posterior a esto se continuó manejo con micofenolato a dosis de 2 gramos/día. Al momento la paciente se encuentra en remisión de la enfermedad con mejoría importante de la limitación funcional y disminución del endurecimiento de la piel después de 2 años de seguimiento.
DiscusiónLa FE es una enfermedad rara del tejido conectivo, los dos primeros reportes fueron realizados en 1974 por Shulman, quien describió un síndrome caracterizado por cambios en la piel, similares a los encontrados en esclerosis sistémica (ES), consistente en induración de las extremidades asociada a aumento en el número de eosinófilos al cual denominó síndrome de Shulman; desde entonces se han descrito más de 300 casos hasta la fecha1,4.
Esta enfermedad afecta por igual a ambos sexos, entre los 40 y 50 años de edad, de predominio en personas caucásicas, si bien puede afectar niños esto se considera excepcional2.
Aunque su causa es desconocida, existen factores desencadenantes los cuales se identifican entre 30-40% de los pacientes. Dentro de estos desencadenantes podemos encontrar un trauma grave, el ejercicio extremo3, la esplenectomía1, así como el uso de algunos medicamentos como las estatinas5, fenitoína6 medicamentos quimioterapéuticos7 e infliximab8.
Adicionalmente, distintos agentes infecciosos se han relacionado, desde las parasitosis intestinales9 pasando por infecciones bacterianas por Mycoplasma arginini y Borrelia burgdorferi10,11.
Otro grupo de enfermedades con el que se ha asociado la FE son las alteraciones hematológicas las cuales pueden encontrarse hasta en el 10% de los pacientes, como la hemoglobinuria paroxística nocturna12, la anemia aplástica13 y la agammaglobulinemia14, así como leucemias15,16 y linfomas17–22. La FE ha sido descrita también después de trasplante de médula ósea23,24, siendo la enfermedad de injerto contra huésped su principal diagnóstico diferencial.
La fisiopatología es desconocida pero se cree que el aumento de los eosinófilos genera un aumento del factor de crecimiento transformante β que va a estimular a los fibroblastos para producir una mayor cantidad de colágeno; asociado a esto se sabe que los pacientes con FE tienen niveles aumentados de proteína inhibidora de metaloproteinasas tipo 1 (TIMP-1), la cual inhibe la degradación del colágeno llevando a una fibrosis de los tejidos, secundaria a una respuesta inmune aumentada1,25. Si bien solo existe un estudio al respecto, en el perfil de citoquinas pareciera ser que hay aumento de niveles de IL-5 y factor de crecimiento transformante β (TGF-β), los cuales fueron documentados en un niño de 3 años con FE, los cuales revirtieron con la mejoría clínica de la enfermedad después del inicio de los esteroides26.
Dentro de las manifestaciones clínicas, los pacientes inician con pérdida de peso (26%), astenia (38%) y mialgias (67%)27. El 90% de los pacientes tienen compromiso en piel y hasta el 60-80% de los pacientes tienen compromiso muscular y articular1. La localización más frecuente de la FE son las extremidades superiores en 88% seguida por las extremidades inferiores en 70% y en menor medida compromiso de tronco y cuello con 32 y 18% respectivamente1,2,4. Esta afección cutánea inicia con eritema, edema y engrosamiento de la piel en las extremidades, de manera simétrica, aunque se ha reportado de manera unilateral28. El compromiso en las extremidades suele respetar la región más distal de estas, no obstante en algunos casos, en especial en los relacionados con trasplante de médula ósea, puede encontrarse edema con fóvea29 en manos o dedos30. Posterior a estos cambios, aparecen los cambios en piel de naranja y finalmente hay una induración marcada, este fenómeno puede llegar a ser tan intenso que se han descrito síndromes compartimentales derivados de la enfermedad31. Se ha reportado la coexistencia de lesiones tipo morfea32, hasta en un tercio de los pacientes y deben considerarse parte de la enfermedad1,4. El signo del surco es patognomónico de esta patología, el cual consiste en una depresión que se forma en el trayecto de las venas superficiales en la región distal de las extremidades y se observa mejor al elevarlas. Este se produce por la separación de la dermis superficial y la epidermis, secundario al proceso fibrótico33,34.
El compromiso extracutáneo de la enfermedad se manifiesta en forma de afección articular en muñecas, codos, hombros, tobillos y rodillas; adicionalmente el proceso fibrótico puede generar contracturas con limitación funcional22, así como síndrome de túnel del carpo por compresión del nervio mediano4,35. La miositis es un hallazgo infrecuente y generalmente se produce por contigüidad del proceso inflamatorio de la fascia36. Otras manifestaciones extraarticulares que se han escrito en casos aislados son el compromiso pleural y pulmonar37, pericárdico38–40 y vascular en forma de gangrena digital41 o vasculitis asociada42,43.
Dentro de los paraclínicos complementarios, el hallazgo más característico es la eosinofilia periférica que se encuentra hasta en el 90% de los pacientes. Esta, sin embargo, no es necesaria para hacer el diagnóstico, no se correlaciona con la gravedad de la enfermedad y no sirve para el seguimiento. También puede encontrarse elevación en los reactantes de fase aguda (proteínaC reactiva y velocidad de sedimentación) e hipergammaglobulinemia en la mitad y un tercio de los pacientes, respectivamente. Dentro de los paraclínicos de autoinmunidad se pueden encontrar anticuerpos antinucleares positivos en títulos bajos hasta en el 20% de los pacientes, usualmente con anti-DNA y ENAS negativos1,2.
Dentro de los exámenes imagenológicos, la resonancia magnética es probablemente el examen que más información aporta44, documentando engrosamiento de la fascia cuyos cambios se relacionan con la actividad de la enfermedad y la respuesta al tratamiento45.
El diagnóstico definitivo de la FE se hace con biopsia de piel que incluya tejido celular subcutáneo y biopsia de fascia muscular. La epidermis usualmente no está afectada. En la dermis reticular profunda y septos subcutáneos puede observarse un infiltrado inflamatorio leve y en algunos casos fibrosis. Los principales hallazgos están a nivel de la fascia superficial donde se observa fibrosis, cambios degenerativos con necrosis o depósito de mucina e infiltrado inflamatorio compuesto por linfocitos y eosinófilos46.
Dentro de los diagnósticos diferenciales encontramos las enfermedades fibrosantes de la piel1, siendo particularmente importante diferenciar esta de una ES por el compromiso orgánico de esta última47. Desde el punto de vista clínico existen 3 signos semiológicos que pueden ser de utilidad en esta tarea: el primero es la ausencia de fenómeno de Raynaud en la FE mientras que es un hallazgo casi universal en la ES. El segundo es la ausencia de compromiso distal en la FE usualmente, mientras que este es el primer sitio de afección en la ES. Finalmente, el tercer signo semiológico, ya descrito previamente, es el signo de la «V» que es relativamente específico para compromiso cutáneo profundo. Otros diagnósticos diferenciales pueden visualizarse en la tabla 1.
El tratamiento se debe realizar de forma temprana para evitar consecuencias a largo plazo y conservar la movilidad de las articulaciones44. Un tercio de los pacientes tienen remisión espontánea27. Los pacientes con lesiones tipo morfea, que inician la enfermedad antes de los 12 años de edad o con compromiso del tronco, presentan mala respuesta al tratamiento y en consecuencia peor pronóstico48.
El tratamiento de primera línea son los esteroides sistémicos (0,5–1,0mg/kg/día), aún no se ha establecido bien el tiempo de duración pero se usan por varios meses o incluso años, con una respuesta parcial o completa en el 70 al 90% de los pacientes1. Mención especial merece el manejo con pulsos de metilprednisolona que han sido usados en el manejo de la FE49 demostrando, en una serie de 34 pacientes, que se asociaban a un mejor pronóstico de la enfermedad si se usaban al inicio del tratamiento27.
Con respecto a los medicamentos ahorradores de esteroides, metotrexate27, azatioprina, ciclosporina50, hidroxicloroquina, sirolimus51, inmunoglobulina14 e incluso inhibidores del factor de necrosis tumoral (infliximab) son considerados medicamentos de segunda línea y su uso está indicado en caso de contraindicación a los esteroides sistémicos o como terapia combinada cuando no hay buena respuesta a estos1,35.
Finalmente, recientemente se publicó un estudio en el que se comparó D penecilamina contra manejo convencional con esteroides, encontrando una mejoría de 19% en contra de 6% de los pacientes tratados solo con esteroides en el compromiso cutáneo, convirtiendo este medicamento, que ha entrado en desuso para otras enfermedades, en una opción interesante para el manejo de esta enfermedad en casos refractarios52.
ConclusiónSe reporta el caso de una paciente con antecedente de esferocitosis hereditaria y esplenectomía, quien presentó una FE extensa, diagnosticada por biopsia profunda y resonancia magnética. De los 300 casos que hay reportados en la literatura se encontró solo un caso de FE desencadenada por una esplenectomía secundaria a una policitemia vera en una paciente femenina, al igual que el caso de nuestra paciente. Además, es de destacar la importancia de la FE como un diagnóstico diferencial de las enfermedades del colágeno, sus posibles asociaciones y desencadenantes, la importancia de un diagnóstico y un tratamiento temprano para evitar consecuencias a largo plazo y saber que se debe realizar una biopsia profunda que incluya fascia ya que la biopsia de piel puede ser normal y retrasar el diagnóstico.
Responsabilidades éticasProtección de personas y animalesLos autores declaran que para esta investigación no se han realizado experimentos en seres humanos ni en animales.
Confidencialidad de los datosLos autores declaran que en este artículo no aparecen datos de pacientes.
Derecho a la privacidad y consentimiento informadoLos autores declaran que en este artículo no aparecen datos de pacientes.
Conflicto de interesesLos autores declaran no tener ningún conflicto de intereses.
Institución donde se realizó el trabajo: Clínica CES y Clínica UPB, Medellín Colombia.